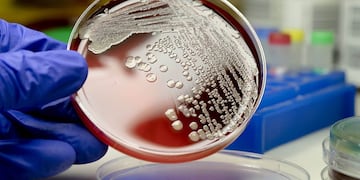

Vía Punta Alta
Última rifa del año para ayudar a un puntaltense con su rehabilitación
Jon Gasc fue operado hace un año de un tumor cerebral y no tiene obra social. En la actualidad se encuentra rehabilitando en el HNPB. Además, con estudios médicos de control. La rifa sale 300 y sorteará el 23 de diciembre, importantes premios, entre ellos un lechón.